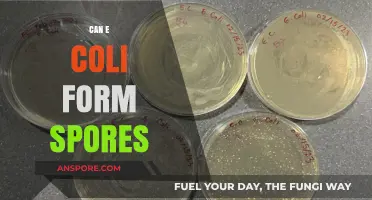
Can E. Coli Form Spores? Unraveling the Bacterial Survival Myth

Frankia, a genus of nitrogen-fixing filamentous bacteria, plays a crucial role in symbiotic relationships with actinorhizal plants, facilitating atmospheric nitrogen fixation in nutrient-poor soils. One of the key questions regarding its life cycle is whether Frankia can form spores. Unlike many other filamentous bacteria, Frankia does not produce traditional endospores, which are highly resistant structures formed within the cell. However, it does form specialized structures known as vesicles, which are thought to serve as survival structures under adverse environmental conditions. These vesicles are not true spores but rather thickened, metabolically inactive cell segments that enhance Frankia's resilience. Understanding the formation and function of these vesicles is essential for comprehending Frankia's survival strategies and its ecological significance in symbiotic associations.
| Characteristics | Values |
|---|---|
| Can Frankia form spores? | Yes |
| Type of spores | Thick-walled, multicellular, and resistant to desiccation and other environmental stresses |
| Function of spores | Serve as a means of dispersal and survival in adverse conditions |
| Location of spore formation | Within specialized structures called vesicles, which are formed on the root nodules of host plants |
| Shape of spores | Globose to ellipsoid |
| Size of spores | 2-5 μm in diameter |
| Sporulation process | Occurs within the vesicles, where hyphal elements differentiate into spore-forming cells |
| Environmental triggers for sporulation | Stress conditions such as nutrient limitation, desiccation, or host plant senescence |
| Role in symbiosis | Spores can germinate and re-establish symbiosis with a new host plant when conditions are favorable |
| Taxonomic distribution | Sporulation is a characteristic feature of the genus Frankia, which includes various species that form symbiotic associations with actinorhizal plants |
| References | Latest research and reviews on Frankia biology and symbiosis (as of October 2023) |
Explore related products
What You'll Learn
- Frankia Sporulation Conditions: Environmental triggers and optimal conditions required for Frankia to initiate spore formation
- Spore Structure: Morphological and cellular characteristics of Frankia spores and their protective features
- Sporulation Mechanism: Genetic and biochemical processes involved in Frankia's spore development and maturation
- Spore Function: Role of spores in Frankia's survival, dispersal, and symbiotic relationships with host plants
- Comparative Sporulation: Differences in sporulation between Frankia strains and related actinobacteria species

Frankia Sporulation Conditions: Environmental triggers and optimal conditions required for Frankia to initiate spore formation
Frankia, a nitrogen-fixing actinobacterium, is known for its symbiotic relationship with certain plants, but its ability to form spores is a fascinating aspect of its life cycle. Sporulation in Frankia is not a constant process; instead, it is triggered by specific environmental conditions, making it a strategic survival mechanism. Understanding these triggers is crucial for researchers and agronomists aiming to harness Frankia's potential in agriculture and soil rehabilitation.
The Role of Stress in Sporulation
Environmental stress acts as a primary catalyst for Frankia sporulation. Nutrient deprivation, particularly nitrogen limitation, is a well-documented trigger. When Frankia senses a scarcity of nitrogen, it initiates spore formation as a means of survival and dispersal. For instance, studies have shown that reducing nitrogen levels in the growth medium to below 10 mM ammonium can significantly induce sporulation. Similarly, desiccation and osmotic stress, such as exposure to high salt concentrations (e.g., 0.5 M NaCl), mimic harsh soil conditions and prompt spore development. These stressors signal to Frankia that its current environment is no longer hospitable, necessitating a dormant, resilient form.
Optimal Conditions for Sporulation
While stress triggers sporulation, optimal conditions are required for efficient spore formation. Temperature plays a critical role, with Frankia strains typically sporulating most effectively between 25°C and 30°C. Lower temperatures (below 20°C) or higher temperatures (above 35°C) can inhibit or delay the process. pH levels also matter; a slightly acidic to neutral environment (pH 6.5–7.5) is ideal. Additionally, the presence of certain carbon sources, such as glucose or sucrose, can enhance sporulation, though excess carbon may divert energy away from spore formation. Researchers often use defined media with controlled nutrient concentrations to study these conditions, ensuring reproducibility and clarity in experimental results.
Comparative Analysis with Other Actinobacteria
Frankia's sporulation process shares similarities with other actinobacteria, such as Streptomyces, but also exhibits unique traits. Unlike Streptomyces, which forms chains of spores (sporangia), Frankia produces single, thick-walled spores within its hyphae. This distinction suggests that while environmental triggers like nutrient deprivation are universal, the mechanisms and structures involved in sporulation vary. For example, Frankia's spores are more resilient to desiccation, reflecting its adaptation to soil environments. Understanding these differences can inform strategies for cultivating and utilizing Frankia in agricultural settings, where its nitrogen-fixing abilities are particularly valuable.
Practical Applications and Takeaways
For practitioners, creating conditions that mimic Frankia's natural sporulation triggers can enhance its use in soil inoculants. For instance, pre-treating Frankia cultures with controlled nitrogen deprivation or mild osmotic stress before application can increase spore production, improving its survival in diverse soil types. Additionally, maintaining optimal temperature and pH during cultivation ensures consistent sporulation. These insights are not just academic; they have practical implications for sustainable agriculture, where Frankia's spores can serve as long-lasting agents of soil fertility. By mastering these conditions, we can unlock Frankia's full potential in ecosystems worldwide.
Are Mold Spores Water Soluble? Unraveling the Science Behind It
You may want to see also

Spore Structure: Morphological and cellular characteristics of Frankia spores and their protective features
Frankia, a filamentous actinobacterium, is known for its ability to form specialized structures called spores under certain environmental conditions. These spores are not merely dormant forms but are highly resilient, enabling Frankia to survive adverse conditions such as desiccation, nutrient deprivation, and temperature extremes. Understanding the morphological and cellular characteristics of Frankia spores is crucial for appreciating their protective features and ecological significance.
Morphologically, Frankia spores are typically oval or cylindrical in shape, with dimensions ranging from 0.5 to 2.0 μm in diameter and 1.0 to 3.0 μm in length. Their size and shape are adapted to facilitate dispersal and attachment to surfaces, enhancing their chances of encountering suitable environments for germination. The spore wall is a key protective feature, composed of multiple layers that provide structural integrity and resistance to physical and chemical stressors. The outermost layer, often rich in sporopollenin, acts as a barrier against UV radiation and enzymatic degradation, while inner layers contribute to osmotic stability and mechanical strength.
Cellularly, Frankia spores exhibit a condensed cytoplasm with reduced metabolic activity, a hallmark of dormancy. This condensation is accompanied by the accumulation of protective molecules such as trehalose, a disaccharide that stabilizes cellular structures and prevents protein denaturation. Additionally, spores contain high levels of dipicolinic acid, which chelates divalent cations and further contributes to their heat and desiccation resistance. The DNA within Frankia spores is also highly organized and protected by DNA-binding proteins, ensuring genetic integrity during prolonged dormancy.
Comparatively, Frankia spores share some similarities with those of other actinobacteria, such as Streptomyces, but also exhibit unique features. For instance, while both produce exosporium-like structures, Frankia spores often have a thicker and more complex spore wall, reflecting their need to withstand the harsh conditions of soil environments. This distinction highlights the adaptive evolution of Frankia spores in response to their specific ecological niche.
Practically, understanding Frankia spore structure has implications for agricultural and environmental applications. For example, inoculants containing Frankia spores can be used to enhance nitrogen fixation in actinorhizal plants, improving soil fertility and crop yields. To maximize efficacy, spores should be stored in a desiccated state at temperatures below 4°C, and rehydration should be performed gradually to avoid osmotic shock. Additionally, ensuring a neutral to slightly acidic pH (6.0–7.0) during application can promote spore germination and symbiosis establishment. By leveraging the protective features of Frankia spores, researchers and practitioners can harness their potential for sustainable agriculture and ecosystem restoration.
Clostridial Toxins: Are They Produced by Spores or Vegetative Cells?
You may want to see also

Sporulation Mechanism: Genetic and biochemical processes involved in Frankia's spore development and maturation
Frankia, a filamentous actinobacterium, is known for its symbiotic relationship with actinorhizal plants, but its ability to form spores has been a subject of scientific inquiry. Recent studies confirm that Frankia can indeed undergo sporulation, a process critical for its survival and dispersal. This mechanism involves a complex interplay of genetic and biochemical pathways, which are triggered under specific environmental conditions such as nutrient deprivation or stress. Understanding these processes not only sheds light on Frankia’s life cycle but also has implications for agricultural and ecological applications.
The sporulation mechanism in Frankia begins with the activation of specific genes that regulate cell differentiation. Key among these are the *whi* (sporulation inhibition) and *ssg* (sporulation-specific genes) gene clusters, which are homologous to those found in other spore-forming bacteria like Streptomyces. These genes control the initiation of sporulation by sensing environmental cues and altering cellular metabolism. For instance, the *whiA* gene acts as a master regulator, repressing vegetative growth while promoting the formation of spore-specific structures. Biochemically, this phase is marked by the accumulation of storage compounds such as trehalose and dipicolinic acid, which confer resistance to desiccation and heat.
As sporulation progresses, Frankia undergoes morphological changes, including the formation of hyphal swellings that eventually develop into mature spores. This process involves the assembly of a protective spore coat, composed of proteins and peptidoglycan layers, which shields the spore from environmental stressors. The maturation phase is biochemically characterized by the activation of enzymes such as sporulation-specific proteases and DNA-protecting proteins, ensuring the spore’s long-term viability. Notably, the timing and efficiency of these processes are influenced by factors like pH, temperature, and oxygen availability, highlighting the adaptability of Frankia’s sporulation mechanism.
Practical insights into Frankia’s sporulation can be applied in agricultural settings, particularly in enhancing actinorhizal plant growth. For example, inoculants containing Frankia spores can be formulated to improve nitrogen fixation in poor soils. To optimize spore production, researchers recommend culturing Frankia in nutrient-limited media at pH 6.5–7.0 and temperatures of 25–30°C, conditions that mimic natural stress triggers. Additionally, co-culturing Frankia with its host plants can enhance sporulation efficiency, as plant-derived signals may stimulate the process. These strategies underscore the importance of understanding sporulation mechanisms for both scientific and applied purposes.
In conclusion, Frankia’s sporulation mechanism is a finely tuned process involving genetic regulation and biochemical adaptations. By dissecting these pathways, scientists can harness the bacterium’s spore-forming capabilities to address agricultural challenges and deepen our understanding of microbial survival strategies. This knowledge not only advances basic microbiology but also opens avenues for sustainable agricultural practices.
Exploring the Mystery: Are Gas Giants New to Spore's Universe?
You may want to see also
Explore related products

Spore Function: Role of spores in Frankia's survival, dispersal, and symbiotic relationships with host plants
Frankias, a genus of nitrogen-fixing bacteria, have evolved a remarkable strategy to ensure their survival and propagation: spore formation. These spores are not merely dormant structures but are highly specialized entities that play a pivotal role in the bacterium's life cycle. When environmental conditions become unfavorable, such as nutrient depletion or desiccation, Frankia initiates sporulation, a process that transforms vegetative cells into resilient spores. This transformation is a critical adaptation, allowing the bacterium to endure harsh conditions that would otherwise be lethal. The spores' ability to remain viable for extended periods underscores their importance in the long-term survival of Frankia.
The dispersal of Frankia is another area where spores prove indispensable. Unlike vegetative cells, which are limited in their mobility and susceptibility to environmental stressors, spores are lightweight and easily dispersed by wind, water, or soil particles. This dispersal mechanism is crucial for colonizing new habitats and establishing symbiotic relationships with host plants. For instance, when spores land in the rhizosphere of compatible plants, they germinate and initiate the formation of root nodules, where they fix atmospheric nitrogen in exchange for carbohydrates from the host. This symbiotic relationship not necessarily relies on spore dispersal but benefits from the spores' ability to reach new plant partners efficiently.
From a comparative perspective, the spore function in Frankia shares similarities with other spore-forming bacteria, such as Clostridium and Bacillus, yet it is uniquely tailored to support its symbiotic lifestyle. Unlike free-living spore-formers, Frankia spores are not just survival structures but also act as agents of colonization, bridging the gap between bacterial persistence and plant interaction. This dual role highlights the evolutionary sophistication of Frankia's spore strategy, which is finely tuned to balance survival and symbiosis.
Practical considerations for leveraging Frankia spores in agricultural settings are worth noting. To enhance soil fertility, inoculants containing Frankia spores can be applied to the root zones of host plants, such as alder or bayberry, at a rate of 10^6 to 10^8 spores per gram of soil. This dosage ensures sufficient colonization without overwhelming the ecosystem. Additionally, maintaining soil pH between 5.5 and 7.0 and adequate moisture levels optimizes spore germination and nodule formation. For researchers and farmers, understanding the spore function of Frankia not only sheds light on its biology but also provides actionable insights for sustainable agriculture and ecosystem restoration.
In conclusion, the spore function in Frankia is a multifaceted adaptation that underpins its survival, dispersal, and symbiotic success. By forming spores, Frankia navigates environmental challenges, expands its ecological reach, and fosters mutually beneficial relationships with host plants. This intricate interplay between bacterial resilience and plant partnership exemplifies the elegance of microbial evolution and offers practical applications for enhancing agricultural productivity and environmental health.
Honey's Hidden Danger: Botulism Spores and Infant Risk Explained
You may want to see also

Comparative Sporulation: Differences in sporulation between Frankia strains and related actinobacteria species
Frankia, a genus of nitrogen-fixing actinobacteria, has long been recognized for its symbiotic relationship with actinorhizal plants. However, its ability to form spores and the mechanisms involved remain less understood compared to other actinobacteria. While some Frankia strains are known to produce spores under specific conditions, the process varies significantly from that of related actinobacteria, such as Streptomyces and Mycobacterium. This comparative analysis highlights the unique sporulation characteristics of Frankia, shedding light on its ecological and evolutionary distinctions.
One striking difference lies in the environmental triggers for sporulation. In Streptomyces, sporulation is typically induced by nutrient depletion, leading to the formation of chains of spores on aerial hyphae. Frankia, however, often requires stress conditions, such as desiccation or temperature shifts, to initiate sporulation. For instance, Frankia alni has been observed to form spores in response to prolonged drought, a trait that likely enhances its survival in soil environments. This adaptive strategy contrasts with the more predictable nutrient-driven sporulation of Streptomyces, reflecting Frankia's specialized niche in plant root nodules and soil ecosystems.
The morphological and structural differences in spores further distinguish Frankia from its relatives. While Streptomyces spores are characterized by their hydrophobic, pigmented surfaces, Frankia spores are often smaller, thinner-walled, and less pigmented. These differences suggest that Frankia spores prioritize rapid germination and symbiosis initiation over long-term dormancy. For example, Frankia spores can germinate within 24–48 hours upon rehydration, a feature critical for establishing symbiosis with host plants in dynamic soil conditions. In contrast, Streptomyces spores may remain dormant for years, a trait suited to their saprophytic lifestyle.
From a practical standpoint, understanding these sporulation differences has implications for agricultural and biotechnological applications. For instance, optimizing Frankia spore production could enhance its use in inoculants for actinorhizal crops like alder and bayberry. Techniques such as controlled desiccation or temperature cycling could be employed to induce sporulation in Frankia cultures, mimicking natural stress conditions. Conversely, the robust sporulation mechanisms of Streptomyces could inspire strategies for preserving Frankia strains in long-term storage, ensuring their viability for future use.
In conclusion, the sporulation of Frankia strains diverges markedly from that of related actinobacteria, reflecting its unique ecological role and evolutionary trajectory. While Streptomyces and Mycobacterium have developed sporulation mechanisms suited to their free-living or pathogenic lifestyles, Frankia's sporulation is finely tuned to its symbiotic existence. By studying these differences, researchers can unlock new strategies for harnessing Frankia's potential in agriculture and biotechnology, while also gaining deeper insights into the diversity of actinobacterial life cycles.
Can Bees Pollinate Spore-Bearing Plants? Exploring the Science Behind It
You may want to see also
Frequently asked questions
Yes, Frankia can form spores, specifically thick-walled resting spores called "vesicles," which are crucial for its survival in harsh conditions.
Spore formation in Frankia serves as a survival mechanism, allowing the organism to withstand adverse environmental conditions such as drought, extreme temperatures, or nutrient scarcity.
Frankia produces spores through a process called "vesicle formation," where specialized cells within the filamentous hyphae develop into thick-walled, dormant structures capable of enduring stress.
No, Frankia spores themselves are not directly involved in nitrogen fixation. Instead, the vegetative (active) cells of Frankia perform nitrogen fixation within root nodules of host plants.